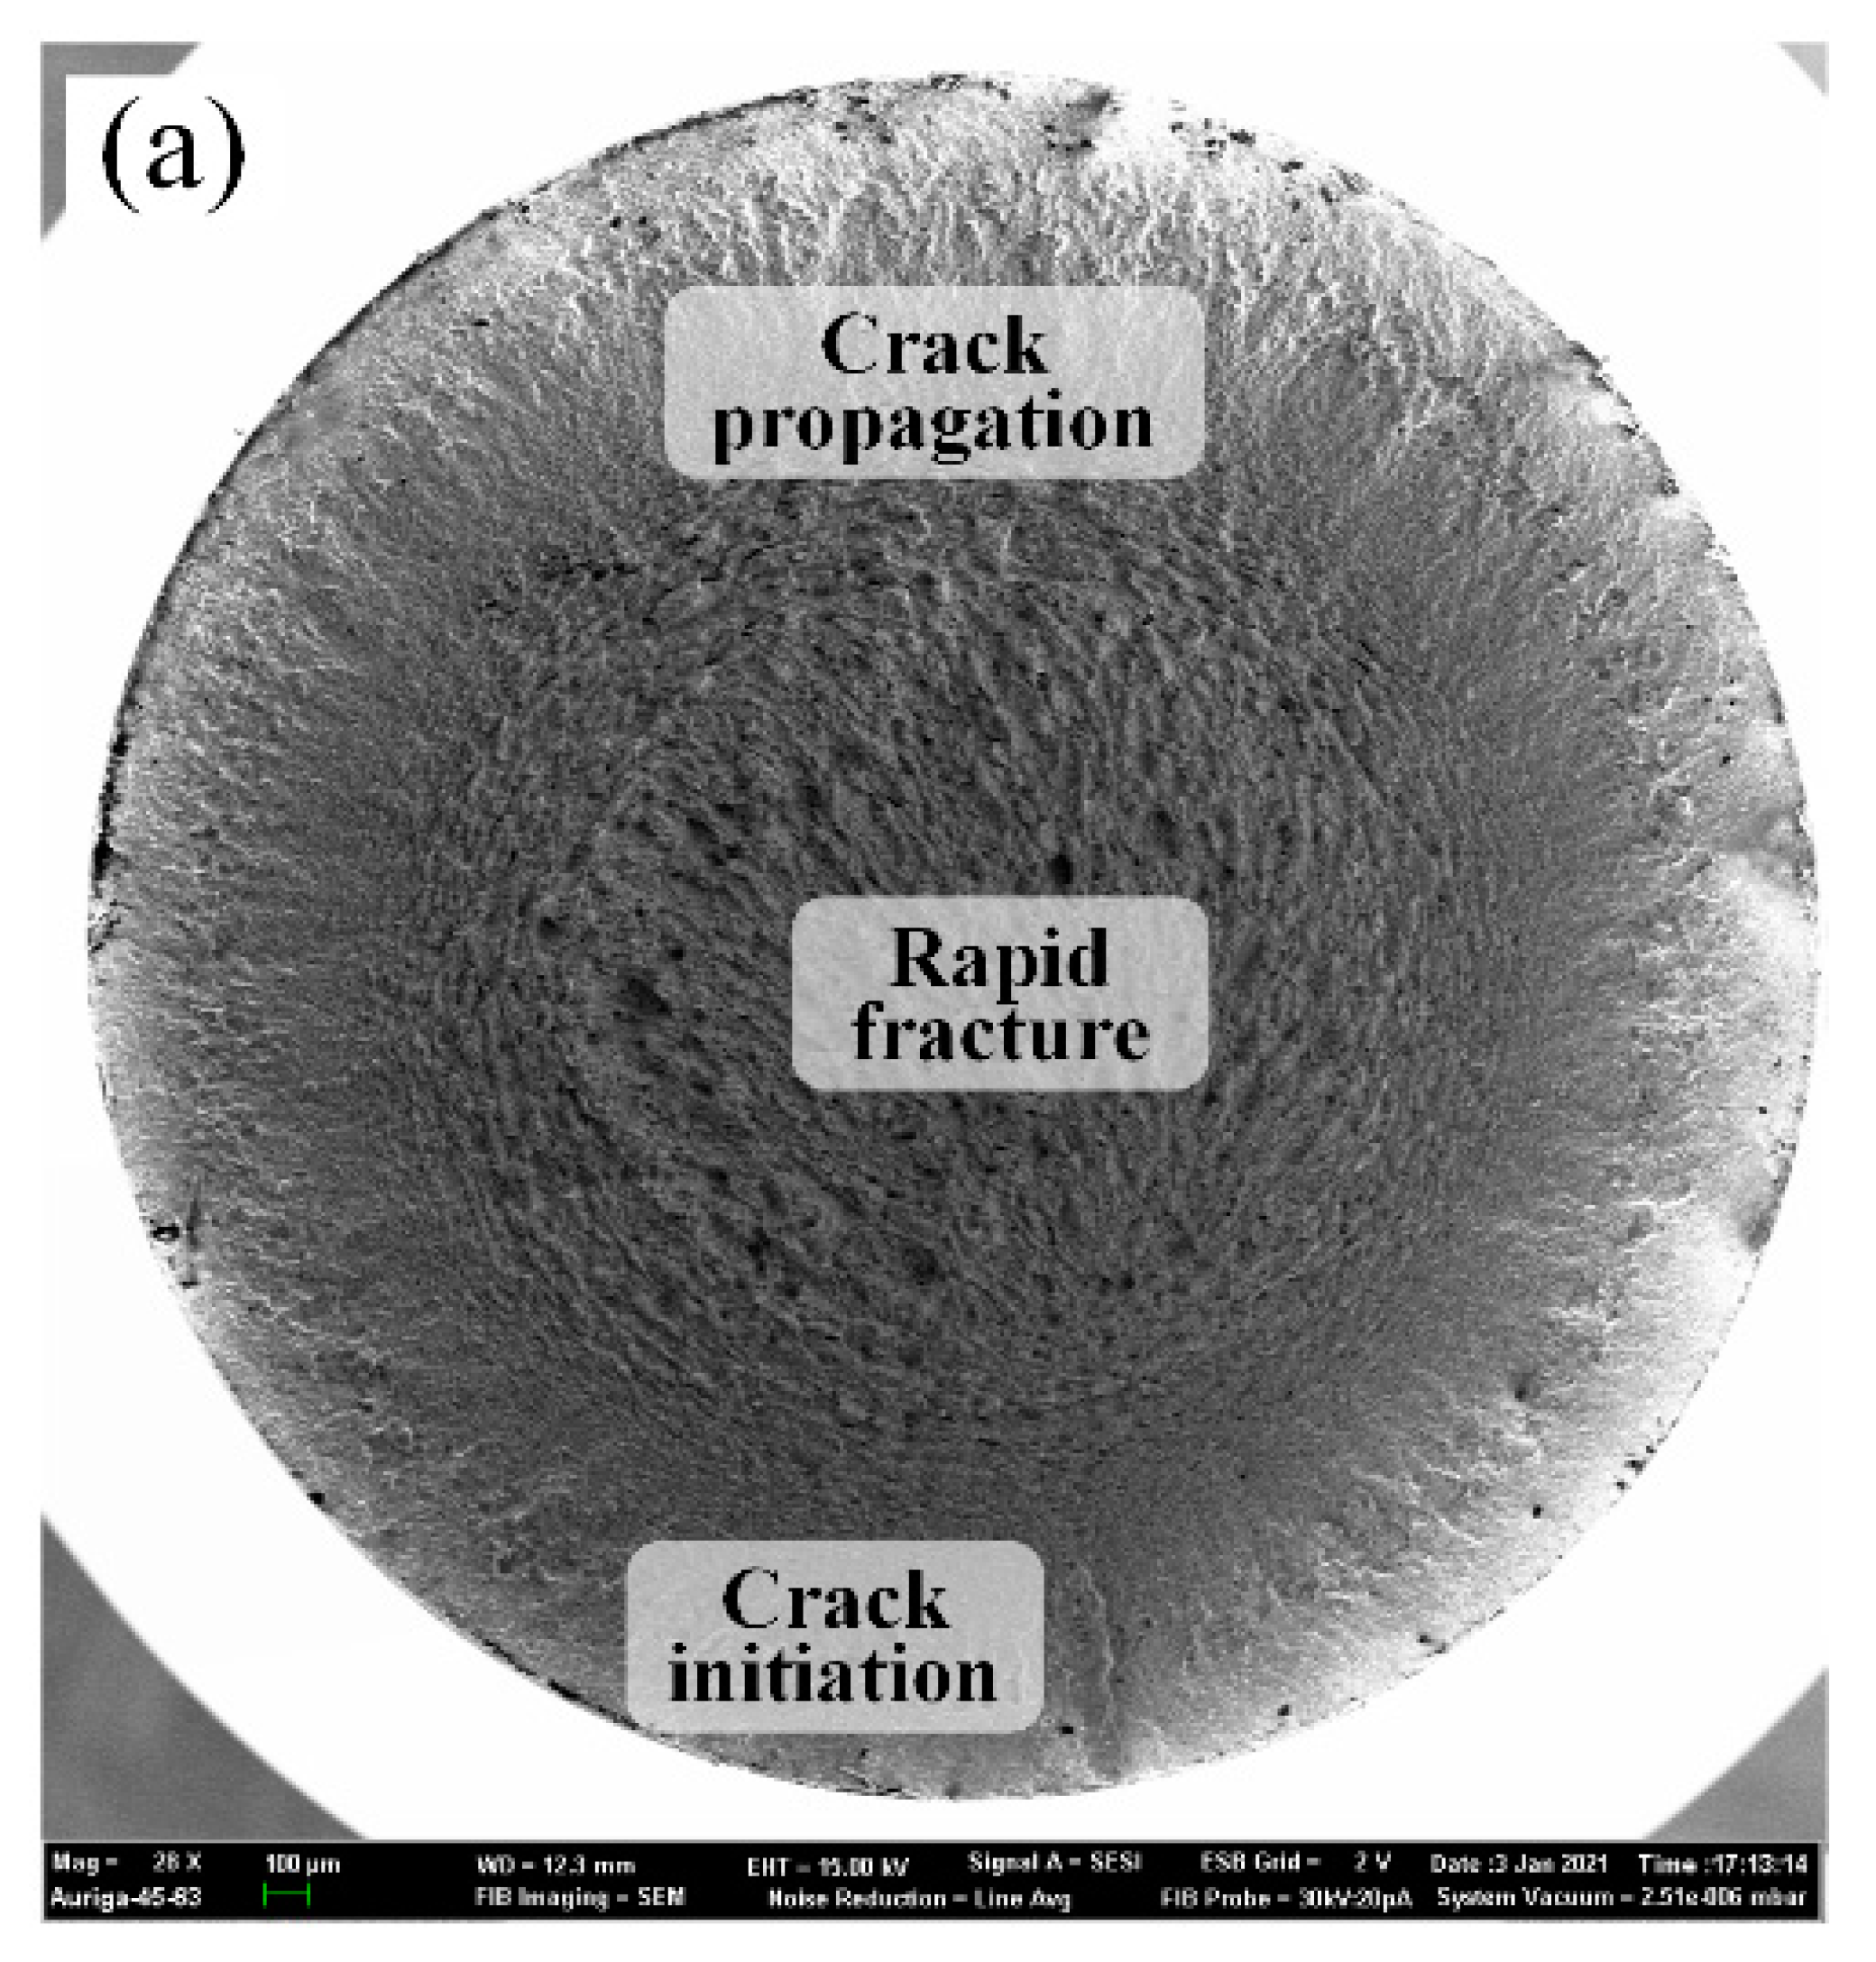
Coatings 13 00809 g013a

Dry Hard Turning versus Grinding—The Influence of Machining-Induced Surface Integrity on Fatigue Performance
Abstract
1. Introduction
2. Experimental Procedures
2.1. Materials
2.2. Dry Hard Turning (DHT) Process
2.3. Grinding Process
2.4. Surface Integrity Characterization and Fatigue Testing
3. Results and Discussion
3.1. Surface Roughness and Morphology
3.2. Residual Stress
3.3. Machining Accuracy
3.4. Fatigue Test and Fractography
4. Conclusions
Author Contributions
Funding
Institutional Review Board Statement
Informed Consent Statement
Data Availability Statement
Conflicts of Interest
References
- Guo, Y.; Yen, D.W. Hard turning versus grinding—The effect of process-induced residual stress on rolling contact. Wear 2004, 256, 393–399. [Google Scholar] [CrossRef]
- Zhang, Y.; Yuan, S.; Yang, X.; Wang, D. Effect of process parameters on hardness and microstructure of 18CrNiMo7-6 carburized steel in high-speed cylindrical grinding. Int. J. Adv. Manuf. Technol. 2022, 124, 3137–3147. [Google Scholar] [CrossRef]
- Hussain, G.; Alkahtani, M.; Alsultan, M.; Buhl, J.; Gupta, M.K. Chip formation, cutting temperature and forces measurements in hard turning of Gcr15 under the influence of PcBN chamfering parameters. Measurement 2022, 204, 112130. [Google Scholar] [CrossRef]
- BBoing, D.; Ganea, A.; Brohede, U.; Stålnacke, E.; Norgren, S. The impact of the retained austenite in the case-hardened steels on the crater wear formation of the PcBN tools. Wear 2021, 476, 203691. [Google Scholar] [CrossRef]
- Guo, Y.; Warren, A. The impact of surface integrity by hard turning vs. grinding on fatigue damage mechanisms in rolling contact. Surf. Coat. Technol. 2008, 203, 291–299. [Google Scholar] [CrossRef]
- Jouini, N.; Revel, P.; Thoquenne, G. Influence of surface integrity on fatigue life of bearing rings finished by precision hard turning and grinding. J. Manuf. Process. 2020, 57, 444–451. [Google Scholar] [CrossRef]
- Peng, Z.; Zhang, X.; Zhang, D. Improvement of Ti–6Al–4V surface integrity through the use of high-speed ultrasonic vibration cutting. Tribol. Int. 2021, 160, 107025. [Google Scholar] [CrossRef]
- Peng, Z.; Zhang, D.; Zhang, X. Chatter stability and precision during high-speed ultrasonic vibration cutting of a thin-walled titanium cylinder. Chin. J. Aeronaut. 2020, 33, 3535–3549. [Google Scholar] [CrossRef]
- Peng, Z.; Zhang, X.; Zhang, D. Performance evaluation of high-speed ultrasonic vibration cutting for improving machinability of Inconel 718 with coated carbide tools. Tribol. Int. 2020, 155, 106766. [Google Scholar] [CrossRef]
- Zhang, X.; Peng, Z.; Liu, L.; Zhang, X. A Tool Life Prediction Model Based on Taylor’s Equation for High-Speed Ultrasonic Vibration Cutting Ti and Ni Alloys. Coatings 2022, 12, 1553. [Google Scholar] [CrossRef]
- Karpuschewski, B.; Schmidt, K.; Beňo, J.; Maňková, I.; Prilukova, J. Measuring procedures of cutting edge preparation when hard turning with coated ceramics tool inserts. Measurement 2014, 55, 627–640. [Google Scholar] [CrossRef]
- Pan, Y.; Kang, R.; Bao, Y.; Yin, S.; Dong, Z. Study on tool wear mechanism of single-crystal diamond in ultrasonic vibration elliptical cutting of tungsten heavy alloy. Wear 2023, 516–517, 204616. [Google Scholar] [CrossRef]
- Tang, L.; Gao, C.; Huang, J.; Shen, H.; Lin, X. Experimental investigation of surface integrity in finish dry hard turning of hardened tool steel at different hardness levels. Int. J. Adv. Manuf. Technol. 2014, 77, 1655–1669. [Google Scholar] [CrossRef]
- Holubjak, J.; Pilc, J.; Czánová, T.; Martikáň, P.; Mital, D.; Mrázik, J. Studying of cutting conditions when hard turning and their impact on integrity of shaped-complex surfaces. MATEC Web Conf. 2018, 157, 05010. [Google Scholar] [CrossRef]
- Kundrak, J.; Gyani, K.; Bana, V. Roughness of ground and hard-turned surfaces on the basis of 3D parameters. Int. J. Adv. Manuf. Technol. 2007, 38, 110–119. [Google Scholar] [CrossRef]
- Martell, J.J.; Liu, C.R.; Shi, J. Experimental investigation on variation of machined residual stresses by turning and grinding of hardened AISI 1053 steel. Int. J. Adv. Manuf. Technol. 2014, 74, 1381–1392. [Google Scholar] [CrossRef]
- Panda, A.; Das, S.R.; Dhupal, D. Surface Roughness Analysis for Economical Feasibility Study of Coated Ceramic Tool in Hard Turning Operation. Process. Integr. Optim. Sustain. 2017, 1, 237–249. [Google Scholar] [CrossRef]
- Sarnobat, S.; Raval, H. Experimental investigation and analysis of the influence of tool edge geometry and work piece hardness on surface residual stresses, surface roughness and work-hardening in hard turning of AISI D2 steel. Measurement 2018, 131, 235–260. [Google Scholar] [CrossRef]
- Smith, S.; Melkote, S.N.; Lara-Curzio, E.; Watkins, T.R.; Allard, L.; Riester, L. Effect of surface integrity of hard turned AISI 52100 steel on fatigue performance. Mater. Sci. Eng. A 2007, 459, 337–346. [Google Scholar] [CrossRef]
- Umbrello, D. Investigation of surface integrity in dry machining of Inconel 718. Int. J. Adv. Manuf. Technol. 2013, 69, 2183–2190. [Google Scholar] [CrossRef]
- Hashimoto, F.; Guo, Y.; Warren, A. Surface Integrity Difference between Hard Turned and Ground Surfaces and Its Impact on Fatigue Life. CIRP Ann. 2006, 55, 81–84. [Google Scholar] [CrossRef]
- Zhang, Y.; Yuan, S.; Wang, Z.; Yang, X.; Gao, W. Experimental analysis of residual stress and hardness of 18CrNiMo7-6 steel in high speed cylindrical grinding. Diam. Abras. Eng. 2021, 41, 65–70. [Google Scholar] [CrossRef]
- Obiukwu, O.; Nwafor, M.; Okafor, B.; Grema, L. The effect of surface finish on the low cycle fatigue of low and medium carbon steel. In Proceedings of the 15th ICMIE Congress, Harare, Zimbabwe, 14–15 July 2015; pp. 2–6. [Google Scholar]
- Fu, P.; Jiang, C.; Ji, V. Microstructural Evolution and Mechanical Response of the Surface of 18CrNiMo7-6 Steel after Multistep Shot Peening during Annealing. Mater. Trans. 2013, 54, 2180–2184. [Google Scholar] [CrossRef]
- Springer, P.; Prahl, U. Characterisation of mechanical behavior of 18CrNiMo7-6 steel with and without Nb under warm forging conditions through processing maps analysis. J. Mater. Process. Technol. 2016, 237, 216–234. [Google Scholar] [CrossRef]
- Wang, G.; Zhang, Y.; Gao, C.; Xu, G.; Zhao, M. Effect of residual stress and microstructure on corrosion resistance of carburised 18CrNiMo7-6 steel. Anti-Corros. Methods Mater. 2020, 67, 357–366. [Google Scholar] [CrossRef]
- Zhao, M.; Han, X.; Wang, G.; Xu, G. Determination of the mechanical properties of surface-modified layer of 18CrNiMo7-6 steel alloys after carburizing heat treatment. Int. J. Mech. Sci. 2018, 148, 84–93. [Google Scholar] [CrossRef]
- Zhang, Y.; Wang, S.; Xu, G.; Wang, G.; Zhao, M. Effect of Microstructure on Fatigue-Crack Propagation of 18CrNiMo7-6 High-Strength Steel. Int. J. Fatigue 2022, 163, 107027. [Google Scholar] [CrossRef]
- Ho, H.S.; Li, D.L.; Zhang, E.L.; Niu, P.H. Shot Peening Effects on Subsurface Layer Properties and Fatigue Performance of Case-Hardened 18CrNiMo7-6 Steel. Adv. Mater. Sci. Eng. 2018, 2018, 3795798. [Google Scholar] [CrossRef]
- Fu, P.; Zhan, K.; Jiang, C. Micro-structure and surface layer properties of 18CrNiMo7-6 steel after multistep shot peening. Mater. Des. 2013, 51, 309–314. [Google Scholar] [CrossRef]
- ISO 1143:2010(E); Metallic Materials-Rotating Bar Bending Fatigue Testing. ISO: Geneva, Switzerland, 2010.
- Peng, Z.; Zhang, X.; Zhang, D. Integration of finishing and surface treatment of Inconel 718 alloy using high-speed ultrasonic vibration cutting. Surf. Coat. Technol. 2021, 413, 127088. [Google Scholar] [CrossRef]
- Peng, Z.; Zhang, X.; Zhang, D. Effect of radial high-speed ultrasonic vibration cutting on machining performance during finish turning of hardened steel. Ultrasonics 2020, 111, 106340. [Google Scholar] [CrossRef]
- Zhang, X.; Peng, Z.; Wang, D.; Liu, L. Theoretical analysis of cooling mechanism in high-speed ultrasonic vibration cutting interfaces. Int. J. Therm. Sci. 2023, 184, 108033. [Google Scholar] [CrossRef]
- Zhang, X.; Peng, Z.; Liu, L. A transient cutting temperature prediction model for high-speed ultrasonic vibration turning. J. Manuf. Process. 2022, 83, 257–269. [Google Scholar] [CrossRef]
- Mikolajczyk, T.; Latos, H.; Paczkowski, T.; Pimenov, D.Y.; Szynka, T. Innovative tools for oblique cutting. Procedia Manuf. 2018, 22, 166–171. [Google Scholar] [CrossRef]
- Mikolajczyk, T. Modeling of Minimal Thickness Cutting Layer Influence on Surface Roughness in Turning. Appl. Mech. Mater. 2014, 656, 262–269. [Google Scholar] [CrossRef]

| Element | C | Si | Mn | S | P | Cr | Ni | Mo | Fe |
|---|---|---|---|---|---|---|---|---|---|
| Content | 0.15–0.21 | 0.15–0.40 | 0.60–0.90 | <0.012 | <0.020 | 1.50–1.80 | 1.40–1.70 | 0.25–0.35 | Bal. |
| No. | Spindle Speed n (r/min) | Cut Depth ap (mm) | Feed Rate vf (mm/min) |
|---|---|---|---|
| 1 | 900 | 0.15 | 30 |
| 2 | 1050 | ||
| 3 | 1200 | ||
| 4 | 1350 | ||
| 5 | 1500 | ||
| 6 | 1200 | 0.05 | 30 |
| 7 | 0.10 | ||
| 8 | 0.15 | ||
| 9 | 0.20 | ||
| 10 | 0.25 | ||
| 11 | 1200 | 0.15 | 10 |
| 12 | 20 | ||
| 13 | 30 | ||
| 14 | 40 | ||
| 15 | 50 |
| No. | Workpiece Speed nw (r/min) | Feed Rate vfr (mm/min) | Spindle Speed (r/min) |
|---|---|---|---|
| 1 | 60 | 0.3 | 1488 |
| 2 | 80 | ||
| 3 | 100 | ||
| 4 | 120 | ||
| 5 | 140 | ||
| 6 | 100 | 0.1 | 1488 |
| 7 | 0.2 | ||
| 8 | 0.3 | ||
| 9 | 0.4 | ||
| 10 | 0.5 |
| Machining Processes | Optimum Parameters | Surface Roughness | Surface Residual Stress |
|---|---|---|---|
| DHT | n = 1500 r/min ap = 0.15 mm vf = 30 mm/min | Ra = 0.174 μm Rq = 0.230 μm | σy = −762.6 MPa σx = −393.6 MPa |
| Grinding | n = 1488 r/min nw = 100 r/min vfr = 0.1 mm/min | Ra = 0.352 μm Rq = 0.440 μm | σy = −406.5 MPa σx = −168.4 MPa |
| No. | Machining Processes | Test Stress/MPa | Fatigue Life/N | Fatigue Fracture (Yes/No) |
|---|---|---|---|---|
| 1 | DHT | 1400 | 1,000,000 | N |
| 2 | 1,000,000 | N | ||
| 3 | 284,588 | Y | ||
| 4 | Grinding | 1400 | 1,000,000 | N |
| 5 | 1,000,000 | N | ||
| 6 | 128,504 | Y |
Disclaimer/Publisher’s Note: The statements, opinions and data contained in all publications are solely those of the individual author(s) and contributor(s) and not of MDPI and/or the editor(s). MDPI and/or the editor(s) disclaim responsibility for any injury to people or property resulting from any ideas, methods, instructions or products referred to in the content. |
© 2023 by the authors. Licensee MDPI, Basel, Switzerland. This article is an open access article distributed under the terms and conditions of the Creative Commons Attribution (CC BY) license (https://creativecommons.org/licenses/by/4.0/).
Share and Cite
Zhang, Y.; Yuan, S.; Yang, X.; Gao, W.; Zhang, M.; Peng, Z. Dry Hard Turning versus Grinding—The Influence of Machining-Induced Surface Integrity on Fatigue Performance. Coatings 2023, 13, 809. https://doi.org/10.3390/coatings13050809
Zhang Y, Yuan S, Yang X, Gao W, Zhang M, Peng Z. Dry Hard Turning versus Grinding—The Influence of Machining-Induced Surface Integrity on Fatigue Performance. Coatings. 2023; 13(5):809. https://doi.org/10.3390/coatings13050809
Chicago/Turabian StyleZhang, Yinxia, Shaoshuai Yuan, Xin Yang, Wei Gao, Mingliang Zhang, and Zhenlong Peng. 2023. "Dry Hard Turning versus Grinding—The Influence of Machining-Induced Surface Integrity on Fatigue Performance" Coatings 13, no. 5: 809. https://doi.org/10.3390/coatings13050809
APA StyleZhang, Y., Yuan, S., Yang, X., Gao, W., Zhang, M., & Peng, Z. (2023). Dry Hard Turning versus Grinding—The Influence of Machining-Induced Surface Integrity on Fatigue Performance. Coatings, 13(5), 809. https://doi.org/10.3390/coatings13050809








